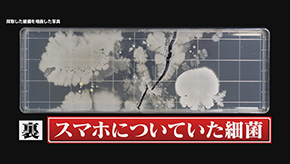

2017年9月29日(金) 放送
着衣着火は、厚着になってくる秋から冬にかけて多発しているというデータがある。具体的には、調理中のガスコンロの火や仏壇のろうそくの火などが、着ている服に燃え移ってしまうという事故が起こっている。しかも、去年着衣着火によって死亡した81人中、約8割が65歳以上の高齢者。

※出典:東京消防庁

※出典:総務省消防庁
神田須田町アイクリニックの吉野真未院長によると、実は近年、高齢による白内障が着衣着火の原因である可能性が指摘されているという。

高齢者の中には白内障になっている人も多く、それにより水晶体が濁ってくると青色系の色を認識しにくくなる。コンロの青い炎も青色系なので、見えにくかったことが原因で着衣着火に至った可能性があるという。青い炎が見えにくくなるとはいったいどういうことなのか?白内障を疑似体験できるゴーグルで見てみると、いかに青い炎が認識しにくいかがわかる。

衣服に着火してしまうと、熱い空気が発生。その熱い空気を一気に吸い込んでしまうと喉をやけどし、火ぶくれができ、最悪の場合窒息死に至ることもあるという。
最初の段階では自覚症状がない、話をすることが出来る人が火ぶくれを起こしたことによって、だんだん具合が悪くなり、意識不明になってしまう。非常に危険でわかりづらいという。
★着衣着火からあなたの命を救う方法(1)
永山さんによると着衣着火を起こさないためには、服の材質などに気をつけたほうがよいという。
綿素材のネルシャツは、低い温度で着火しやすいので注意が必要。麻やレーヨンも低温着火の可能性があるとのこと。


★着衣着火からあなたの命を救う方法(2)
カーディガンのような毛羽立っている素材は、激しく燃える危険があるので注意が必要とのこと。
★着衣着火からあなたの命を救う方法(3)
鼻毛が焦げていないかチェックし、焦げた形跡があった場合は危険。そういう場合はすぐに専門の病院に行き、治療診察を受けたほうがよいという。
昨今の登山ブームと共に増えているのが、遭難。警視庁の調べによると、ここ10年間で遭難者の数は、なんと1.6倍以上に増加。しかもこのデータの遭難者数は、救助要請があったものなど、警察が把握している案件のみの人数。
山岳ガイドの橋谷晃(はしや・あきら)さんによると、実際には、救助要請は至らないものの、道に迷い、最終的には無事に出てきたような“隠れ遭難”といった件数が多くあるという。数字には反映されない隠れ遭難で命を落とさないために、状況に応じて適切な判断が必要。
★隠れ遭難からあなたの命を救う方法
遭難してしまった場合の生死を分ける選択問題を出題。
秋晴れのある日。夫婦でハイキングにやってきた鈴木さん。山頂でお弁当を食べ、景色を楽しみながら下山をしていると、どうやら道に迷ってしまったらしい。とりあえず、来た道を戻ろうとした瞬間、妻が足をひねってしまった。
【問題】くじいてしまった足を応急処置で、とるべき行動は?
A.足を温める
B.足を冷やす
【正解】B.足を冷やす
芝大門いまづクリニック今津嘉宏院長によると、足をひねると、筋や靭帯が切れて内出血を起こし、腫れや痛みなどの症状が出てくる。そこで、患部を冷やすことによって、炎症が広がるのを抑え、腫れや痛みを軽減することが出来る。一方、患部を温めると、血流を促進してしまい、腫れや痛みを悪化させる危険があるという。
足を冷やしているうちに、日が暮れてきてしまった。妻は、まだ歩けず、携帯もつながらない状態。
【問題】この時、とるべき行動は?
A.夫が助けを呼びに行く
B.妻と一緒にその場にとどまる
【正解】B.妻と一緒にその場にとどまる
橋谷さんによると、暗くなるとさらに怪我をしたり、余計に道に迷ってしまう危険があるので、むやみに動き回らず、その場にとどまった方が良い。実際に無事に生還された方は、その場にとどまっていた方が多いという。
無理をせず、妻と一緒にその場にとどまることにした鈴木さん。
【問題】眠る時、身体の下に敷くなら、次のどれ?
A.ビニール袋
B.新聞紙
C.リュックサック
正解 C.リュックサック
橋谷さんによると、リュックサックは、柔らかいマットのような素材が使われている。保温性断熱性に優れ、腰の部分が厚めに作られているので、上下を逆さまにし、クッション部分を枕がわりに使うのがおすすめという。
B.新聞紙は、土の水分を吸収し、すぐに湿ってしまう。
A.ビニール袋は、防水できても、断熱機能はないので、体温が奪われてしまう。
もし、新聞紙やビニール袋を持っている場合、新聞紙は、保温性をいかして服の上に巻き付ける。ビニール袋は、防水性をいかし、上からかぶって夜露を防ぐという使い方も。


1中身をだし、肩紐を最大限に伸ばす。
2上下逆さまにして肩紐に両脚を通す。
3その状態で、怪我人をおんぶする。
肩紐がお尻を支えてくれるので、手を添えなくてもおんぶすることが出来るという。
夜が明け、辺りがずいぶん明るくなってきた。妻の足の状態も少しよくなってきたようだ。
【問題】登山道に戻るためにとるべき行動は?
A.上に向かって歩く
B.下に向かって歩く
【正解】A.上に向かって歩く

橋谷さんによると、道に迷ったら、まず、わかるところまで元来た道を戻ることが大原則。登山道は、基本頂上に向かって収束、下に向かって放射状に分散している。そのため、下山中、道に迷った場合、上に向かった方が登山道にぶつかりやすいという。
道に迷ってから16時間。ようやく登山道を発見。こうして、鈴木さん夫婦は無事に隠れ遭難から抜け出すことが出来た。
もし隠れ遭難してしまった場合は、とるべき行動を覚えておこう。

ハイキングで沢の水で手や顔を洗ったりすると、それが原因である寄生虫に身体を蝕まれる危険があるという。これは、実際に寄生され肝臓の約50%の機能を失ってしまった人のCT画像。

※出典:北海道立衛生研究所
北海道立衛生研究所 八木欣平先生によると、沢の水などに含まれている寄生虫の正体は、エキノコックスだという。エキノコックスとは、長さ3mm程度の糸くずのような白い寄生虫。この寄生虫の卵が体内に入ることで、エキノコックスに寄生されてしまう。
八木先生によると、エキノコックスは主に肝臓に寄生し、潜伏期間は約10年ととても長い。エキノコックスは、肝臓の組織を破壊しながら長い年月をかけ増殖。徐々に肝臓の機能を低下させ、発熱、食欲不振、黄疸などの肝機能障害を引き起こし、最悪の場合、死に至ることも。
そして、このエキノコックスを持っているのが北海道に生息するキタキツネ。八木先生によると、エキノコックスに感染しているキタキツネのフンが泥や水に溶け込んで雨で流され、沢水に混ざり合うことがあるという。キタキツネのフンの中には、大きさ0.03mmのエキノコックスの卵が含まれており、そのフンが川に流れ込み、そして、その水に触れることで口から体内に入り感染してしまう。
八木先生によると、実は、北海道だけでなく、本州でも発症例があるという。北海道と本州を結ぶ青函トンネル開通以降、青森県をはじめ、東京、大阪、さらには、沖縄までも感染者が出ている。
★エキノコックスからあなたの命を救う方法
八木先生によると、沢の水は、そのまま飲むことを避け、野山に行った際には、良く手を洗うこと。エキノコックスの卵は、手洗いやシャワーで簡単に落ちるため、感染リスクを下げることが出来るという。沢水に触れた時には、しっかり手洗いしてエキノコックスを洗い流しましょう。
今年の夏。愛知県で発生したスーパーセル。スーパーセルとは、全長数十キロにも及ぶ巨大な積乱雲のこと。

天達さんによると、上空と地上でものすごく温度差が大きくなることが1つのポイント。この上下の温度差により、大きな積乱雲が出来る。その中には、スーパーセルと呼ばれるような長時間、台風や激しい突風が起こる積乱雲が出来る事も。とくに、これから秋から晩秋にかけては、温度差が大きくなる場合が多いので、特に注意が必要という。
一度、スーパーセルに飲み込まれると、たたきつけるような大粒の雨、強風。そして、落雷。このスーパーセルでは、約7000回もの落雷があり、火災などの被害も出たという。
落雷事故は、ゴルフ場、グラウンドなどで起きるケースが多い。周りに遮蔽物がない場合の落雷は、とくに注意が必要という。

★落雷からあなたの命を救う方法
和田さんによると、落雷を避けることは不可能。雷が落ちにくい場所を判断し移動する事が大切。高い木や建物の下で立っていると、木から自分へ感電する可能性が。高い木や建物の近くに避難する際は、真下に入るのではなく、4m以上の離れた保護範囲に身を置くことが大切。
海外でよく見かける巨大竜巻。それが、今、日本でも。今年、愛知県豊橋市で、突如竜巻が発生。この竜巻により、大型トラックが横転。さらに、コンビニの窓ガラスが大破するなどの被害が。
天達さんによると、実は、竜巻というのは、1年の中でも9月~10月が一番多く発生している。特に、寒暖差が大きくなる季節は注意が必要という。
災害対策の専門家和田さんは竜巻の危険性について、突然、竜巻が発生して、瞬間的に風速65km以上の風が起こる。道端に落ちているちょっとしたゴミでも強風に飛ばされれば凶器にかわるという。愛知県豊橋市のコンビニ被害は、暴風で吹き飛ばされた瓦が窓を突き破ったことが原因だという。
★竜巻からあなたの命を救う方法
【問題】道路を歩いていた時、目の前に竜巻が発生。どうする?
A.道路脇に伏せる
B.ビルの影まで走って隠れる

【正解】B.ビルの影まで走って隠れる
和田さんによると、風は低い場所より高い場所の方が強くなる。道路脇に伏せるのも悪くないが、ポイントは、「道路を歩いていた場合」という条件。台風5号の豊橋市の例や2012年の茨城県つくば市で発生した竜巻では、乗用車を簡単に吹き飛ばし、ゴロゴロと道路を転がった。道路にしゃがみ込むと、目の前を車が転がってくるようなケースも考えられる。
さらに、路上では竜巻によってちぎられた電線から電流という危険も。もし、遭遇したら周りを見渡し落ち着いて、鉄筋の大きなビルや団地などの影に隠れるのが良い。竜巻の速度は、平均時速36kmとされている。もちろん、人の走る速度よりは速いが、近くのビルへ走るくらいの余裕はあるという。
和田さんによると、窓ガラスが割れることで家全体が吹き飛ばされてしまう可能性があるという。
わずか1か所でも家の中に風が入り込む場所があると、空気が入り込み家全体を吹き飛ばしてしまう。家は外からの衝撃には強いが、中からの力には対応していない。対策は、雨戸を閉めること。雨戸がない場合は、飛散防止フィルムを貼るなどの対策を。
細菌やウイルスに詳しい東京医科大学 兼任教授 中村明子先生によると、スマートフォンは一見きれいに見えるが、実はかなり汚いものだという。その原因の一つは、スマートフォンをトイレで使うこと。実はトイレの水を流すと、水しぶきが周囲に飛び、それとともに細菌やウイルスが散乱。風通しもなく狭い室内のため、そこに留まった細菌やウイルスがスマートフォンにも着いてしまうという。
中村先生によると、スマートフォンの表面では大量に菌やウイルスが増殖するようなことはないが、一度付着した菌やウイルスは、汚れ具合にもよるが1日程度ではいなくなることはないので注意が必要という。
トイレには、食中毒を引き起こしかねない細菌やウイルスが存在することがあるという。典型的なノロウイルス。細菌であれば、サルモネラ菌、大腸菌、感染している人であればO-157も出てくることも。
トイレの後に手を洗っても、スマートフォンを触れば、細菌やウイルスがまた手に付着してしまい、食べ物を通し体内へ入ってしまう可能性があるという。
★スマホ食中毒からあなたの命を救う方法
中村先生によると、定期的にアルコールシートなどで拭いて除菌することが大切。スマートフォンの端の窪み、さらに裏面は、絶えず手で握っているので、表より細菌やウイルスが残りやすいので、表だけではなく裏もきちんと拭いてきれいにしましょう。
山中さん(仮名)夫婦は、結婚して30年。ごくごく一般的な家庭を築いていた2人。ある日のこと。夫が帰宅。いつものように夕食をたべようとすると、口げんか。この日の夫婦げんかはいつも以上にヒートアップ。さっきまで、威勢の良かった妻が、突然、心臓をおさえ、呼吸も荒い。慌てて救急車を呼び、すぐに病院へ。
神戸労災病院 井上信孝副院長によると、たこつぼ心筋症を発症していたという。たこつぼ心筋症とは、心臓がたこつぼのようになってしまう病。


たこつぼ心筋症を発症したひとの心臓
通常の心臓に比べ、根元部分だけが収縮し、心室の先端部分が全く動かない状態になってしまう。これにより、胸の痛みや吐き気、呼吸困難などの症状が出るという。
井上先生によると、この病気は、女性に多いのが特徴という。たこつぼ心筋症の発症者の約9割が女性。急激なストレスを受けた際に、過剰に分泌されるホルモンの影響で引き起こされるとのこと。閉経によってホルモンのバランスの乱れた50歳以上の女性が特に注意する必要があるという。
★たこつぼ心筋症からあなたの命を救う方法
井上先生によると、急激なストレスを受けた場合は、ゆっくりした腹式呼吸をすることをすすめるという。その方法は、お腹を意識しながら、4秒間息を吸い、8秒間かけて息を吐くというもの。これを繰り返すことで、自律神経が整い、気持ちを落ち着かせてくれるという。
井上先生によると、たこつぼ心筋症は、適切に治療すると、2~3週間ほどで良くなる病気。何か症状があった場合は、すぐに病院へ。

写真提供:FCG総研 川上博士
池袋大谷クリニック大谷義夫院長によると、アスペルギルス症とは、カビ界最恐と言われるアスペルギルス・フミガータスが引き起こす病。
(1)医師でも診断が難しい
大谷先生によると、専門医でないと診断出来ないケースがほとんど。実際に症状が出てから診断が下されるまで、7~8年を要した患者が多々報告されているという。
(2)肺に住み着き浸食
アスペルギルスは、肺に入ると気管支を炎症させ拡張させてしまう。それにより、周囲の肺胞を圧迫し肺の機能を失わせてしまうという。
(3)修復できない
肺には再生機能がないため、一度浸食されてしまうともとには戻らないという。
実は、私たちが過ごしやすい秋は、カビも活発になり、対策が重要になる季節。家庭のカビ・ダニの専門家エフシージー総合研究所 農学博士 川上裕司博士によると、アスペルギルス・フミガータスは、元々、土壌に住み、土ぼこりから家の中へと侵入。家のほこりなどに溜まるため、部屋の隅、棚の上など重点的に掃除することが大切とのこと。
【問題】アスペルギルス症の対策が最も必要な場所は?
A.寝室
B.キッチン
C.トイレ
【正解】A.寝室
1日約8時間ほど、その空気を吸って寝ている寝室は、最も対策が必要な部屋。なかでも盲点になるのがベッド。川上さんによると、ベッドというのは万年床。当然、汗や垢、フケが溜まる。ベッドは、まさにアスペルギルスの格好の住みかという。
★アスペルギルス症からあなたの命を救う方法
ベッドマットローテーション。2週間に一度、ベッドマットを回転させ、頭側、足側、表側、裏側と4回のローテーションをさせる方法。
回転する前は、ベッドマットを風通しの良い場所に立てかけ、マットに溜まった湿気を抜くこと。マットについたほこりを掃除機で吸ってあげるとさらに効果的。この方法でカビだけではなく、咳やアレルギーの原因になるダニやハウスダストも防ぐことができるという。


カビ、ダニ、ハウスダストがピークに達するのが9月。10月は換気がしやすく洗濯物がカラッと乾くこの季節に大掃除をするのがベスト。
日本は世界有数の火山列島。気象庁によると111の活火山が点在し、世界の1割を超える火山が集まる危険地域。それゆえ、いまだ火山災害による犠牲者は後を絶たないという。
火山の研究などを専門とする武蔵野学院大学 島村英紀先生によると、火山の噴火予知というのは非常に難しく、前兆がなくても、いきなり噴火した例の方が非常に多い。御岳山の場合にも警戒レベルを上げないままで、今回の噴火が起きてしまったという。
火山はいつ噴火するかわからず、十分に警戒していても目の前で起これば、瞬く間に巻き込まれてしまう。
そこで、2004年の中規模噴火をはじめ、過去100年間で50回以上の噴火を繰り返している長野県浅間山に登り、火山が噴火するとどんな危険があり、どう命を救うのか学ぶことに。
今回案内してくれる浅間山に200回以上登ったというベテラン山岳ガイド下谷博さんによると、命を守るために装備、持ち物は非常に大切という。それは、水、ライト、ゴーグル、マスク、タオルの5つ。さらに、ヘルメット、手袋をつけて準備完了。
登山口には、噴火警戒レベルを示した看板が設置されている。噴火警戒レベルとは、火山の状況を5つのレベルに分類したもの。気象庁のHPで確認することが出来るとのこと。
浅間山は、現在、レベル2。火口から2km以内は立ち入り禁止。そのため、今回は、浅間山の火口からわずか3kmの黒斑山(くろふやま)を登ることに。当然、浅間山が噴火すれば、命の危険は十分あるという。

いよいよ火山に足を踏み入れる。山のいたるところに冷え固まった溶岩が。道幅が狭く、石が多い山道は、逃げる際、転倒しやすく非常に危険。
しばらく進むと、林を抜け、視界が開けた場所に到着。
噴火による危機(1) 隕石
爆発的な噴火によって火口から飛ばされる岩石。その速さは、時速300km以上と言われ、握り拳ほどの石が雨のように降り注ぐ。さらに恐ろしいのが、時には、人の背丈を超える巨大な隕石が飛んでくることも。
★隕石からあなたの命を救う方法
岩陰に隠れ、ザックなどで頭を守りながら身を小さく屈める。隕石は、火口からまっすぐ飛んでくるので、火口に向かって正面に隠れるのがポイント。プロのガイドは、常に隠れられそうな岩陰をチェックしながら登っているという。


または、山によってシェルター(避難壕)が設置されている。浅間山周辺のシェルターは、暑さ3cmの鉄板で出来ており、20人ほどが逃げ込める広さがある。こういった場所も、あらかじめ登山地図で確認しておくことが大切。
登山から3時間。目の前に浅間山(前掛山)。晴れていれば火口から噴煙が立ち上がる様子がうかがえる。
噴火による危機(2)火山灰
噴火と共に舞い上がる火山灰。その直径はわずか2mm。吸い込むとガラス繊維のような粒が肺に入り、呼吸困難を引き起こすことも。さらに、広範囲にわたって農作物や市街地に大きな被害を与える。

★火山灰からあなたの命を救う方法
噴火と共に舞い上がる危険な火山灰に有効なのは、出発前に用意していたゴーグルと防塵マスク。もし、ゴーグルやマスクがない時、タオルを水で濡らして代用できる。目に入るのを防ぐため、鼻や口だけでなく、顔全体を覆うことが重要。
そして、忘れてはいけないのがライト。御嶽山の噴火直後の映像を見ると、火山灰に巻き込まれると一瞬にして辺り一面真っ暗に。ライトがなければ、30cm先も見えない状況だったという。救助活動の時、動けなかった40代の男性が、ライトを使って、自らの居場所を知らせることが出来たという。
荷物や装備を万全にして、安全に登山を。
先月のたった1週間で1万人以上が感染。この秋から冬にかけて過去最多の感染者数を更新するという予測も。感染すると、強い咳、鼻水、発熱を引き起こし、最悪の場合、死に至るという。
杉並堀ノ内クリニック粂川好男先生によると、このRSウイルスは、インフルエンザより非常に怖い感染症と考えられているという。
インフルエンザより怖い理由(1) 感染力
インフルエンザは通常、症状がなくなる期間は約1週間。しかし、RSウイルスは、その期間が倍の2週間。そのため、咳や鼻水で感染するリスクが高まるという。実際にアメリカの研究では、1シーズンにRSウイルスの患者は、インフルエンザの2倍という研究結果も。この強い感染力により、介護施設などで集団感染も発生。死者を出すこともあり、非常に危険。

インフルエンザより怖い理由(2) 肺炎
粂川先生によると、RSウイルスはインフルエンザよりも高齢者に感染すると肺炎などを引き起こすという。ある研究によると、高齢者でRSウイルスにかかった人のうち、肺炎になった割合は、インフルエンザよりも多いという結果が。肺炎でなくなる約95%は、65歳以上と言われ、高齢者は特に注意が必要。
粂川先生によると、インフルエンザウイルスは、鼻や喉で増殖するのに対し、RSウイルスは、肺の奥で増殖するため肺炎を引き起こしやすいという。
★RSウイルスからあなたの命を救う方法
粂川先生によると、RSウイルスのワクチンと治療法はまだ開発されていないため、マスク、しっかりと手洗い、うがいをすることで、感染を防ぐことが大切とのこと。
この番組は専門家の監修のもとに構成いたしました。
番組で紹介した事例は身体の悩みに関する原因とそれに対する解決策の1つです。事例により別の原因・学説があることをご承知ください。
医療行為を試される場合は医師に相談の上ご本人の正しい判断で行ってください。